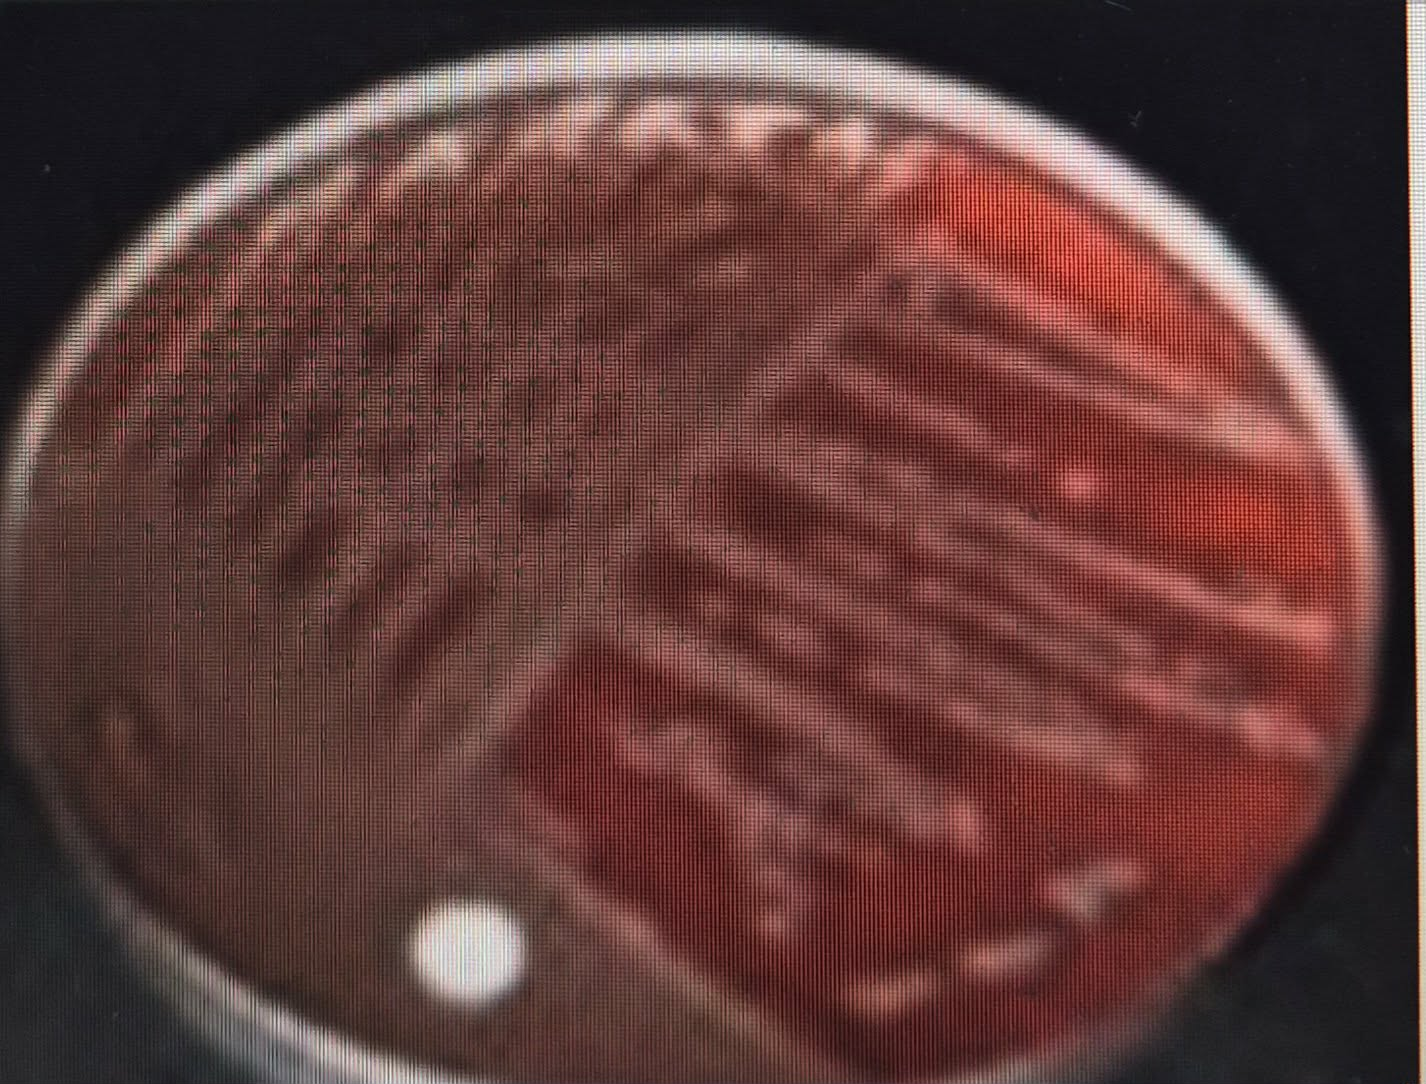
knowt flashcard image

ALPHA-HEMOLYTIC STREPTOCOCCI
1/16
There's no tags or description
Looks like no tags are added yet.
Name | Mastery | Learn | Test | Matching | Spaced | Call with Kai |
|---|
No analytics yet
Send a link to your students to track their progress
17 Terms
(Streptococcus pneumoniae) (capsule) (ANTI-PHAGOCYTIC) (ANTI-
COMPLIMENTARY)
• A diplococcus organism (two cocci organisms attached to
each other).
• Its morphology is coffee bean/kidney bean shape.
• It is capsulated, the diplococcus is surrounded by an unstained
area called (_______).
o The virulence mechanism of capsule as a bacterial
structure is (____________) AND (______________) so that means the organism is
not destroyed by the phagocytes and the
complement system.
o It survives inside the body and has the potential to
cause infection to the human host
Streptococcus viridans/Viridans
streptococci
• Also, diplococcus
• it does not have any CAPSULE.
o Staining the capsule of the microorganism will also
positively identify that the unknown
diplococci/unknown alpha- hemolytic streptococci is
of Streptococcus
(Pneumoniae)
between the two, Streptococcus (__________) is the capsulated
streptococcus.
PLEOMORPHIC
• The arrangement of Streptococcus viridans can be
(___________) under the microscope. It is very important
for the source of the specimen to be reported so that the
laboratory will know how to undergo the investigation of the
alpha-hemolytic streptococci
(hemolytic pattern) (ALPHA-HEMOLYSIS) (greenish brown)
PRESUMPTIVE TESTS
• The (______________)
of Streptococcus pneumoniae and
Streptococcus viridans is (____________) which is the
incomplete destruction of the RBCs and that will cause
(______________) discoloration to the blood agar medium
brought about by the oxidation of the hemoglobin molecule
or the formation of methemoglobin in the blood agar
medium.
(Hiss Capsular Staining) (Anthony’s method) (Plasma) (heat fix the
entire smear)
B. (________________)
• A modification of (_______________).
• In this test, make a smear out from the sample received in the
laboratory and the sample is already suspected of having an
alpha-hemolytic streptococci organism using a clean glass slide
but instead of adding NSS in making the bacterial smear,
(________) is used in making the smear.
(3) (______) is used to cause swelling of the capsule of the
organism. After a smear was made using (3) (__________) as the
reagent, it is allowed to air dry it and do not (__________) cause
shrinkage of the capsule which causes difficulty in the
identification of the capsule in this staining technique.
(Carbol Fuchsin) (wash the entire bacteria) (20% copper sulfate) (+) (pneumoniae)
Hiss Capsular Staining Proper
1) Primary stain: (__________)
2) Heat the antibacterial smear to steaming for 5 minutes
and then we do not (_______________) smear
because it might shrink the capsule
3) Decolorizer: (___________) for 5 minutes and
allow the entire bacterial smear to air dry and check under
the microscope for the appearance of diplococcus
organisms surrounded by an unstained area which is
capsule.
4) (____) - diplococcus surrounded by an unstained area
(capsule of the organism), presumptively identifies (__________)
(Optochin Sensitivity Test) ()
C. (____________)
• Differentiate Streptococcus pneumoniae from
Streptococcus viridans
• although only presumptive because there are other organisms
outside of streptococci family or of alpha-hemolytic that will
also present same result with Streptococcus pneumoniae.
(P disc) (1:4000) (ethylhydrocupreine
hydrochloride) (6mm)
Optochin, otherwise known as (________)
If optochin is not available,
(______) solution of (____________) can be added to a filter paper
and the filter paper is allowed to air dry and cut
the saturated filter paper into paper disks with
(_______) as the thickness.
(susceptible/resistant)
• If there are zone of inhibition around the P disc they are
measured to know if the organism is (________)
(Bile Solubility Test) (sodium deoxycholate) (1 MCFARLAND STANDARD) (AMIDASE) (lysis) (clear)
CONFIRMATORY TESTS
(___________________)
Source of Bile: (_______________)
1) Make a bacterial suspension. The turbidity of the bacterial
suspension used in the bile solubility test should be comparable
to (_____________) to qualify the correct
procedure. Divide the bacterial suspension into 2 test tubes;
one is labeled control and the other is labeled test
2) In the bacterial suspension label test, 5-10 drops (2) (___________) is added. The bacterial suspension labeled
control is not treated with any reagent.
3) After 5-10 mins of adding the sodium deoxycholate to the test
tube labelled control, check for the clearing of turbidity/lysis of
the organism in the test tube.
4) Streptococcus pneumoniae organism has an autolytic
enzyme (autolysis) inside called (__________). That autolytic
enzyme gets stimulated if there is bile in the surrounding.
5) If the bacterial suspension are tested (already turbid) is added
with bile salt sodium deoxycholate and the organism in that
bacterial suspension is Streptococcus pneumoniae, the
autolytic enzyme in the organism amides gets stimulated and
the amides will cause (______) of the Streptococcus pneumoniae in
the bacterial suspension so that after a few minutes, from
turbid appearance it will become (______).
(Morphology) (Streptococcus pneumoniae)

(Morphology) (Streptococcus viridans/ Viridans
streptococci)

(Optochin Susceptibility Test) (Streptococcus pneumoniae)

(Optochin Susceptibility Test) (Streptococcus viridans/ Viridans streptococci)
(Bile Solubility Test) (Streptococcus pneumoniae)

(Bile Solubility Test) (Streptococcus viridans/ Viridans
streptococci)
